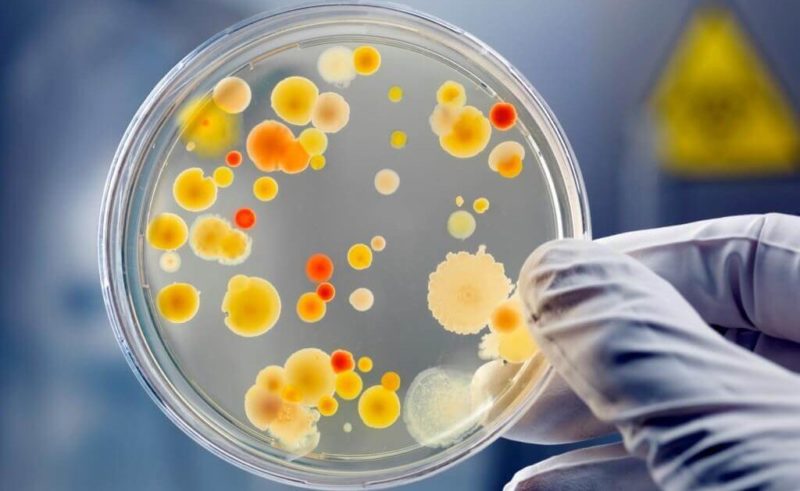
Антибактериальные средства для ванн для ног

Ванны для ног – неотъемлемая и важная часть процедуры педикюра. Они могут не только размачивать кожу, но и оказываться дезодорирующее, увлажняющее или заживляющее действие. Разбираемся, какие средства для ванночек бывают и как правильно их применять.
Важность педикюрных ванн


Все представленные в магазинах препараты для ванн можно разделить на:
- Увлажняющие;
- Дезодорирующие;
- Заживляющие;
- Противогрибковые;
- Разогревающие;
- Против отеков;
- Антибактериальные;
- Комбинированные.
Действие ванночки напрямую зависит от компонентов состава. Ромашка, к примеру, обладает противовоспалительным эффектом, а выжимка чайного дерева помогает в профилактике и лечении грибковых инфекций.
Средства для педикюрных ванн выпускаются в нескольких форматах:
- Жидкий лосьон, крем или гель. Препарат, как правило, концентрированный, поэтому его небольшое количество разводится с большим количеством воды;
- Соль. Привычный вариант для ванн в виде крупных соляных гранул;
- Шарики. Шипучие шарики, напоминающие соляные бомбочки для ванн.
Пошаговая инструкция
Как принимать ванночки для ног со средствами:
- Приготовь ёмкость с теплой водой. Оптимальная температура – от 37 до 40 градусов. Контролировать температуру можно вручную термометром, но лучше использовать электрическую ванночку – она будет поддерживать нужную температуру на протяжении всей процедуры;
- Добавь необходимое количество концентрированного средства для педикюрных ванн. Точное количество написано на упаковке препарата. К примеру, бренд Camillen 60 рекомендует разводить из расчёта 5 мл препарата на 5 литров воды;


- Опусти ноги в ванночку и оставь на 10-15 минут;
- Достань ноги из воды. Отполируй ступни пемзой, используй скраб или просто смажь увлажняющим кремом;
- Надень плотные носочки.
Виды средств для педикюрных ванн


Как уже говорилось, продукты могут иметь кроме основной функции – размачивания, и вспомогательную, к примеру, увлажнение или заживление. Выбирая средство, обращай внимание именно на ту категорию, которая будет кстати в данный момент. И еще пару советов в выборе:
- Обращай внимание на состав. Лучше, чтобы ухаживающие компоненты, например, экстракт шалфея, был ближе к началу списка. Чем раньше в составе упоминается компонент, тем выше его концентрация;
- Соизмеряй объем. Если ты выбираешь средство для домашнего использования, бери небольшие упаковки – 250,500 мл. Для салона, наоборот, лучше покупать упаковки сразу большого объема – от 1000 мл. Это выйдет дешевле, чем покупать новую упаковку после каждых 10 клиентов;
- Изучай инструкцию к каждому конкретному средству, а также соблюдай рекомендации по частоте использования. Это особенно касается препаратов, разработанных для салонов красоты – в их составе высокая концентрация активных компонентов, которые не подходят для ежедневного применения.
Увлажняющие


В состав увлажняющих препаратов входят:
- Масла – абрикосовое, кокосовое и другие;
- Глицерин – вещество, задерживающее влагу в коже;
- Мочевина;
- Пантенол;
После использования увлажняющих средств:
- Уменьшается или полностью прекращается шелушение;
- Кожа становится мягкой, эластичной;
- Ступни становятся мягкими и нежными.
Использование увлажняющих продуктов показано тем, чья кожа склонна к сухости, а также в холодное время года.
Дезодорирующие


Пара важных моментов о дезодорирующих средствах:
- Добиться заметного результата получится только при регулярном использовании. Желательно проводить процедуру не реже 3-4 раз в неделю;
- При повышенном потоотделении используй комплексный подход и сочетай педикюрные дезодорирующие ванны с использованием дезодорантов и кремов, регулирующих потоотделение. Все необходимые препараты предлагает, к примеру, немецкая компания Геволь, где представлена освежающая ванна, антиперсперанты и кремы с нужным эффектом.


Заживляющие


В средствах для педикюрных ванн в качестве заживляющих компонентов используются:
- Витамины группы В и E;
- Эфирные масла – тимьяна, розмарина, чайного дерева;
- Экстракты – календулы, шиповника.
Чаще всего средства с заживляющим эффектом выпускаются в форме соли. К примеру, Заживляющая соль мертвого моря от Зейтун.


Противогрибковые


В состав препаратов входят компоненты с антибактериальным эффектом:
- Масло чайного дерева;
- Гвоздика;
- Мята;
- Имбирь.
Для профилактики развития грибка рекомендуется использоваться ванны 1 раз в неделю, для лечения – каждый день до полного выздоровления.
Разогревающие


Справиться с проблемой помогут ежедневные педикюрные ванны с согревающими компонентами:
- Красный перец;
- Имбирь.
Эти компоненты улучшают приток крови к ступням и справляются с проблемой холодных конечностей. Использовать согревающие препараты лучше систематически, а иначе – проблема вновь вернется, и будет доставлять дискомфорт. Немецкий бренд Геволь преуспел и в создании разогревающих препараторов для ванн, а также в виде кремов и гелей.


Против отеков


Для облегчения симптомов и устранения отеков используй средства с:
- Зеленым чаем;
- Ромашкой;
- Мятой.
После использования продуктов для ванночек против отеков наблюдается устранение лишней жидкости со стоп, а также появление чувства легкости. Всего этого поможет добиться, к примеру, Средство для ножных ванночек от Spa Ceylon.


Антибактериальные

В качестве антибактериальных компонентов используются:
- Экстракты брусники, имбиря, гранат – природные антибиотики;
- Корица – иммуномодулирующий компонент с эффектом тонизирования;
- Шалфей, календула, эвкалипт.
Антибактериальный компонент не обязательно должен быть природного происхождения. Часто в составе подобных препаратов используется тетранил.
Talaris предлагает пену для ножных ванн, где активным антибактериальным компонентом является как раз тетранил.


Комбинированные


Некоторые производители предлагают продукты для ванн с комбинированным эффектом. Один препарат помогает увлажнить кожу, уменьшает выделение пота и регулирует кровообращение. Состав таких препаратов разнообразен и может включать масла, травяные экстракты, пантенол, витамины.
Яркий пример комбинированного средства – соль для ножных ванночек с корицей от Floslek. Соль обладает антисептическим, разогревающим и увлажняющим свойством.


Профессиональные средства


Как уже говорилось, приобретать для салонов лучше средства специально для этого предназначенные. Во-первых, так получится намного выгоднее, во-вторых, профессиональные препараты гарантируют результат, а значит, не обманут ожидания клиента. При всем многообразии товаров для педикюрных ванн, выбрать подходящий продукт непросто. Для того, чтобы облегчить твой выбор, мы подобрали несколько качественных и реально работающих препаратов.
Gehwol
Профессиональный немецкий бренд специализируется на проблемах ног и предлагает огромный выбор средств. Есть в ассортименте компании и товары для педикюрных ванн.
Ванна для ног «Миндаль Ваниль» с выраженным увлажняющим эффектом. Выпускается в упаковках разного объема от 50 мл до 1 литра. Стоимость самой большой фасовки – около 4 000 р.


Травяная ванна с лавандой и розмарином используется для размягчения загрубевших мозолей. Выпускается в пакетиках по 20 грамм, каждый из которых рассчитан на одну процедуру. Самая крупная фасовка 10 килограмм, а это 500 процедур, обойдется в 14 000 руб.


Крем-ванна с лавандой справляется с усталостью и отечностью. Средство хорошей концентрации – для одной процедуры потребуется всего 1 ст. л. на 4 литра воды. Объём – от 150 до 2000 мл. Самая большая упаковка на официальном сайте оценивается в 6840 р. Бутыли хватит для проведения более 100 процедур.


Aravia
Профессиональная косметика Aravia используется в салонах красоты, маникюрных кабинетах и студиях. Бренд отличается относительной дешевизной, при этом предлагая продукты хорошего качества.
Гель с морской солью от Аравии выпускается только в одном формате – флаконе 300 мл. Для процедуры требуется 15 мл средства на 4 литра воды. Экономный расход и низкая цена делают средство привлекательным салонов красоты. Стоимость упаковки – от 250 до 400 рублей.


Kinetics
Российский бренд предлагает товары для маникюра и педикюра, а также ухаживающие продукты.
К примеру, SPA-средство Pro Soak с экстрактом имбиря используется для проведения ножных ванн. Действие направлено на размягчение мозолей и натоптышей перед их удалением. Выпускается в формате 225 и 900 мл. Цена – 570 и 1900 р. соответственно.


Farmona
В части ножных ванн производитель отдает предпочтением солям и предлагает несколько вариантов продукта с разным действием.
Соль разогревающая для ванны с маслом корицы улучшает кровообращение и имеет долговременный эффект. Рекомендуется для использования 1-2 раза в неделю. Упаковка 600 мл на официальном сайте стоит около 500 рублей.


Грейпфрутовая соль для ванн из линейки Smooth Feet смягчает кожу и улучшает прилив крови. Выпускается в удобной банке с закручивающейся крышкой объемом 1500 мл по цене от производителя 1 600 р.


Средства для ванн – спасение для женщин, чьи ступни нуждаются в дополнительном увлажнении или уходе. Расскажи в комментариях, какое у тебя любимое средство для ножных ванн!